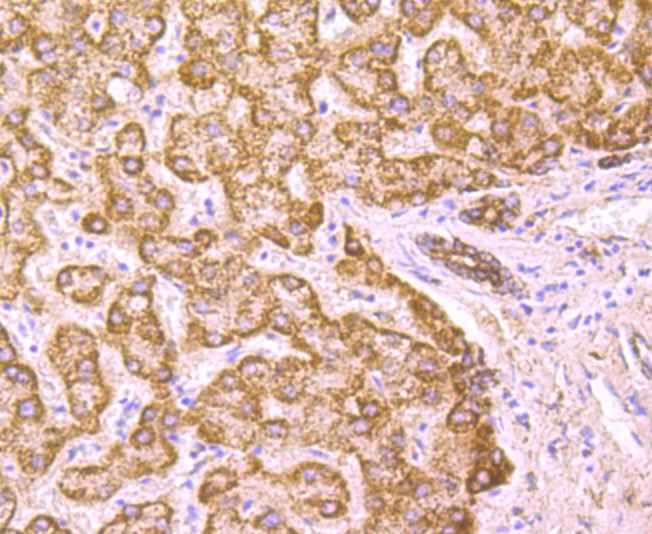

PCSK9 Mouse Monoclonal Antibody(ARA994)
CAT.NO. : ARA6899
RMB Please choose
RMB Please choose
Background
PCSK9 is a proprotein convertase belonging to the proteinase K subfamily of the secretory subtilase family. This protein is synthesized as a soluble zymogen that undergoes autocatalytic intramolecular processing in the endoplasmic reticulum. The protein may function as a proprotein convertase. The protein plays a role in cholesterol homeostasis and may have a role in the differentiation of cortical neurons.
Application
|
Application |
Dilution Ratio |
|
WB |
1:1000 - 1:5000 |
|
IHC |
1:200 - 1:500 |
Overview
|
Antibody Type |
Mouse Monoclonal Antibody |
|
Immunogen |
Recombinant protein with Human PCSK9 1-201 / 692. |
|
Species Reactivity |
Human, Mouse |
|
Validated Applications |
WB, IHC, IF |
|
Molecular Weight |
Predicted band size: 74 kDa |
|
Positive Control |
HepG2 cell lysate, K-562 cell lysate, HepG2, human liver tissue, human colon caner tissue, human kidney tissue, mouse kidney tissue. |
|
Conjugation |
unconjugated |
|
Form |
Liquid |
|
Storage Buffer |
1×PBS (pH7.4), 0.2% BSA, 50% Glycerol. Preservative: 0.05% Sodium Azide. |
|
Isotype |
IgG2b |
|
Purification Method |
Protein A affinity purified. |
Data

Western blot analysis of PCSK9 on different lysates with PCSK9 Mouse Monoclonal Antibody(ARA994).

Immunohistochemical analysis of paraffin-embedded human liver tissue using PCSK9 Mouse Monoclonal Antibody(ARA994).

Immunohistochemical analysis of paraffin-embedded mouse kidney tissue using PCSK9 Mouse Monoclonal Antibody(ARA994).
Storage
Store at +4℃ after thawing. Aliquot store at -20℃. Avoid repeated freeze / thaw cycles.
Research Use Only
For Research Use Only. Not for use in diagnostic procedures.
 New Products
New Products